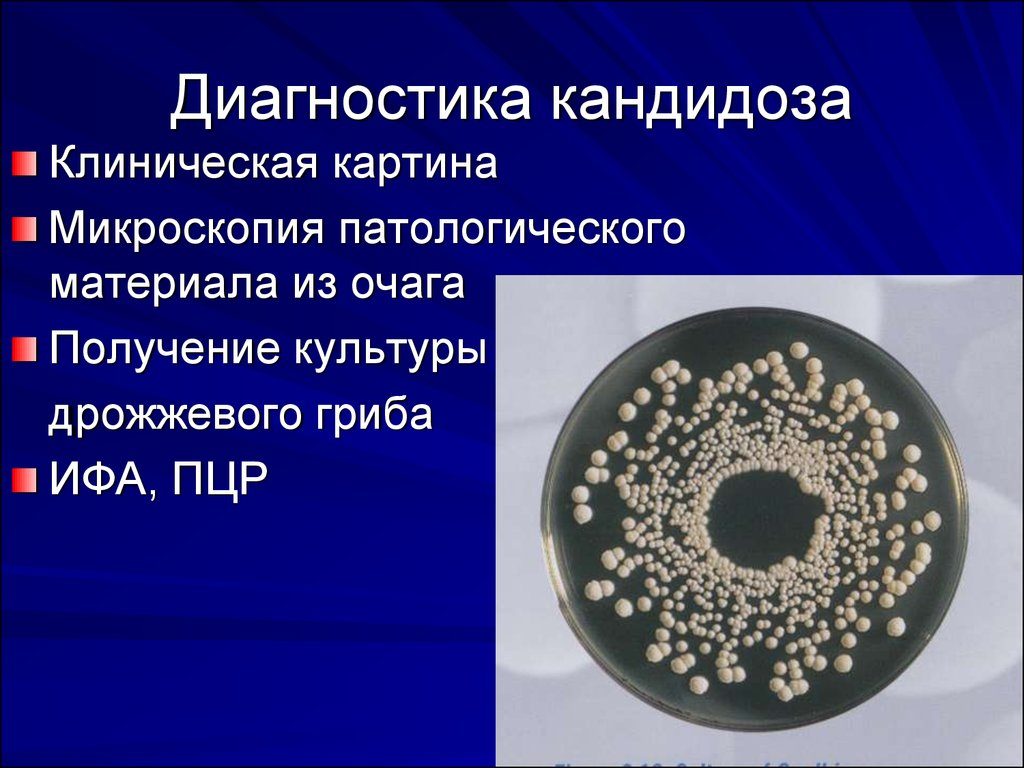

Кандидозы у женщин: симптомы и лечение народными средствами (фото)
Рассмотрим, почему возникают кандидозы у женщин, каковы их первые симптомы и какое лечение поможет. Выясним, какие методы используют для терапии и профилактики этого недуга.
Причины возникновения молочницы
Факторы, влияющие на развитие кандидоза кроются в целом ряде причин. Далеко не всегда наличие в организме возбудителя говорит о самом заболевании.

Активизация дрожжевого грибка может происходить в нескольких случаях, рассмотрим их более подробно:

Симптомы и внешние проявления кандидоза у женщин
Признаки проявления кандидоза невозможно не заметить, в период заболевания молочницей, из влагалища отмечаются сильные выделения, имеющие белый цвет. Этот процесс сопровождается весьма ощутимым зудом и жжением. Возможно появление боли во время мочеиспускания.
Кандидозы у женщин в гинекологии принято рассматривать в комплексе симптомов, а лечение назначать только после обследования.

Рассмотрим основные из них:
Несмотря на расхожее заблуждение, грибы Кандида способны образовываться не только в женском организме, молочница способна активизироваться у мужчин и детей, учтите это при выборе лечения.

Молочница при беременности
Кандидозы у женщин в период беременности, как правило, появляются за счет увеличения количества гормонов. Само по себе время вынашивания ребенка, вызывает некоторое угнетение иммунной системы.
Симптомы и лечение при таких особенностях организма будет несколько отличаться.
Важно знать:

Диагностика кандидоза
Несмотря на то, что признаки молочницы, принято считать однозначными, требуется провести соответствующее обследование, чтобы поставить точный диагноз.
Провести подобные обследования способен только врач, и только в лабораторных условиях:
- для определения наличия грибков Кандида, со слизистой оболочки влагалища берется мазок на флору;
- в этих же целях, а также для определения подвида возбудителя болезни, проводится анализ бакпосева;
- в целях определения благоприятной среды, изучаются анализы крови и мочи на содержание сахара.
Лечение кандидоза у женщин
По сути, лечение молочницы сводится к восстановлению баланса микрофлоры организма, кандидозы у женщин встречаются довольно часто, симптомы хорошо изучены, а лечение может быть как медикаментозным, так и проводиться при помощи народных средств:

Во многих случаях при наличии кандидоза у женщин успешно удается уменьшить симптомы и провести лечение народными средствами.
Отзывы специалистов о таком способе терапии, говорят об успешном применении отваров трав в комплексе лечения молочницы.

Как уже говорилось выше, заболевание молочницей не является исключительно женской болезнью. Нередко специалисты диагностируют:
- кандидозы у женщин и детей во рту, симптомы и лечение при этом похожи, а излечение возможно при применении исключительно народных методов;
- кандидозы у женщин и мужчин в паху — как правило подобные симптомы возникают одновременно у половых партнеров, а лечение проходит параллельно.

Профилактические меры для предупреждения молочницы
Принято считать, что предупреждение заболевания является гораздо более простым делом. Профилактические процедуры будут полезны задолго до проявлений кандидоза, так и после излечения болезни.
Вот самые эффективные из них:
- соблюдение личной гигиены;
- сбалансированное питание;
- прием лекарственных препаратов только по рекомендации специалиста;
- уменьшение потребления сладкого и мучного;
- отказ от тесной одежды;
- использование специализированных средств интимной гигиены;
- использование каждодневных прокладок.

Фитодиета для больных кандидозом
Помимо известных методов излечения от молочницы, хорошим подспорьем может стать употребление в пищу природных антисептиков, а также некоторые ограничения, способствующие восстановлению здорового баланса организма:
- в период лечения необходимо ограничить употребление хлеба, молочных продуктов, картофеля;
- исключить из рациона сладкое;
- максимально увеличить потребление витаминов, особенно группы В;
- построить диету на потреблении свежих овощей и фруктов;
- ежедневное употребление настоев шиповника, календулы, березовых почек;
- замена привычных напитков на травяные чаи на основе эвкалипта, лаванды, фенхеля.

Ванны и ванночки для лечения молочницы
Действенным средством лечения кандидоза у женщин являются сидячие ванны. Полезнее всего проводить их перед сном. Эффект от использования ванночек, длится достаточно долго и признан официальной медициной. Для приготовления ванны используется отвар из трав чабреца, укропа и лепестков розы в равных частях. Полезно добавление эфирных масел ореха и сандалового дерева.
В заключении необходимо напомнить, что самолечение может привести к осложнениям. При малейших признаках возникновения заболевания следует обратиться к врачу.

А вы знаете какими препаратами лечить молочницу?
Да
Нет
Я не сталкивалась с такой проблемой
Проголосовать